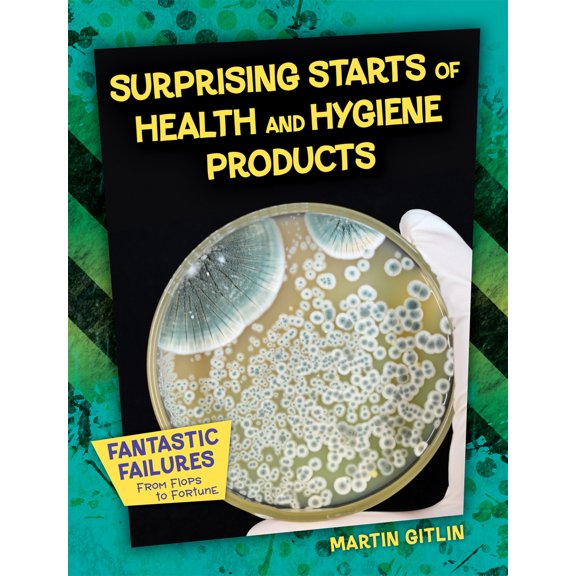
Pre-Owned Surprising Starts of Health and Hygiene Products (Library Binding) 1668938243 9781668938249

Pre-Owned BooksPre-Owned Children's BooksReference BooksAccounting BooksAdvertising & Promotion BooksAfrican History BooksAges 3-5 Children's BooksAges 3-5 Kids' BooksAges 6-8 Kids' BooksAges 9-12 Kids' BooksArchitecture BooksArt BooksArt Techniques BooksArts & Humanities BooksAsian History BooksBusiness & Money BooksBusiness & Money Development BooksCollectible Comics N.E.Commerce Business & Investing BooksConsumer Behavior BooksDesign BooksEconomic Conditions BooksEconomic History BooksEconomics BooksEnvironmental Economics BooksEuropean History BooksFinance BooksFood & Beverage History BooksGame & Activity BooksGeneral Business & Money BooksGeneral Language Arts & Disciplines BooksGeneral Philosophy BooksGeneral Political BooksGreen Business BooksHistory BooksHouse & Home BooksIndustries BooksInternational Business & Money BooksLabor Business & Money BooksLanguage Arts & Disciplines BooksLatin American History BooksLiterary Collection BooksLiterary Criticism BooksManagement BooksMarketing BooksMedieval History BooksMiddle Eastern History BooksMilitary History BooksModern History BooksMovements in Philosophy BooksNature BooksNew Age & Spirituality BooksPerforming Arts BooksPhilosophy BooksPhotography BooksPolitical BooksPolitical Economy BooksPolitical Ideology BooksPoliticsPottery & Ceramics Crafts & Hobbies BooksPublic Finance BooksPublic Policy Political BooksPurchasing & Buying Business & Money BooksRecycling & Green Living Kids' BooksReligion & Religious Studies BooksRevolutionary History BooksSales & Selling BooksScience BooksSocial History BooksSocial Science BooksTechnology & Engineering BooksUnited States History BooksWomen's History BooksWorld History Books
Sort by|
Pre-Owned BooksPre-Owned Children's BooksReference BooksAccounting BooksAdvertising & Promotion BooksAfrican History BooksAges 3-5 Children's BooksAges 3-5 Kids' BooksAges 6-8 Kids' BooksAges 9-12 Kids' BooksArchitecture BooksArt BooksArt Techniques BooksArts & Humanities BooksAsian History BooksBusiness & Money BooksBusiness & Money Development BooksCollectible Comics N.E.Commerce Business & Investing BooksConsumer Behavior BooksDesign BooksEconomic Conditions BooksEconomic History BooksEconomics BooksEnvironmental Economics BooksEuropean History BooksFinance BooksFood & Beverage History BooksGame & Activity BooksGeneral Business & Money BooksGeneral Language Arts & Disciplines BooksGeneral Philosophy BooksGeneral Political BooksGreen Business BooksHistory BooksHouse & Home BooksIndustries BooksInternational Business & Money BooksLabor Business & Money BooksLanguage Arts & Disciplines BooksLatin American History BooksLiterary Collection BooksLiterary Criticism BooksManagement BooksMarketing BooksMedieval History BooksMiddle Eastern History BooksMilitary History BooksModern History BooksMovements in Philosophy BooksNature BooksNew Age & Spirituality BooksPerforming Arts BooksPhilosophy BooksPhotography BooksPolitical BooksPolitical Economy BooksPolitical Ideology BooksPoliticsPottery & Ceramics Crafts & Hobbies BooksPublic Finance BooksPublic Policy Political BooksPurchasing & Buying Business & Money BooksRecycling & Green Living Kids' BooksReligion & Religious Studies BooksRevolutionary History BooksSales & Selling BooksScience BooksSocial History BooksSocial Science BooksTechnology & Engineering BooksUnited States History BooksWomen's History BooksWorld History Books
Consumption Goods(252)
Uses item details. Price when purchased online
Consumption and the World of Goods, (Paperback) $145.40

$14540
current price $145.40Consumption and the World of Goods, (Paperback)
Monuments as Consumption Goods (Paperback) $34.14

$3414
current price $34.14Monuments as Consumption Goods (Paperback)
ZORBX Unscented Odor Eliminator Spray for Hospitals & Healthcare Dog, Cat, Car & Carpet Deodorizer (16oz - Pack of 2) $29.97

$2997
current price $29.97ZORBX Unscented Odor Eliminator Spray for Hospitals & Healthcare Dog, Cat, Car & Carpet Deodorizer (16oz - Pack of 2)
13 out of 5 Stars. 1 reviews
Save with
pink dog $14.95

$1495
current price $14.95pink dog
Save with
American Crafts Sweet Sugarbelle Celebrate Coloring Book Edible Images $10.08

$1008
current price $10.08American Crafts Sweet Sugarbelle Celebrate Coloring Book Edible Images
APC - Heavy Duty All Purpose Cleaner & Degreaser

APC - Heavy Duty All Purpose Cleaner & Degreaser
Consumption : How To Prevent It And How To Live With It: Its Nature, Its Causes, Its Prevention, And The Mode Of Life, Climate, Exercise, Food, Clothing Necessary For Its Cure (Hardcover) $32.00

$3200
current price $32.00Consumption : How To Prevent It And How To Live With It: Its Nature, Its Causes, Its Prevention, And The Mode Of Life, Climate, Exercise, Food, Clothing Necessary For Its Cure (Hardcover)
Dipsters Women's Bibb-Top with Shorts Patientwear, XX-Large $94.81

$9481
current price $94.81Dipsters Women's Bibb-Top with Shorts Patientwear, XX-Large
Save with
The Defensor Pacis of Marsiglio of Padua; Volume 8 (Paperback)

The Defensor Pacis of Marsiglio of Padua; Volume 8 (Paperback)
Save with
Pre-Owned World of Goods : Towards an Anthropology of Consumption (Paperback) 9780713911633 $22.19

$2219
current price $22.19Pre-Owned World of Goods : Towards an Anthropology of Consumption (Paperback) 9780713911633
Practice of Consumption and Spaces for Goods (Paperback) $36.08

$3608
current price $36.08Practice of Consumption and Spaces for Goods (Paperback)
Save with
B & H Publishing Group 63429 Commun Fellowship Cup Prefilled Juice Wafer Box Of 100 $39.08

$3908
current price $39.08B & H Publishing Group 63429 Commun Fellowship Cup Prefilled Juice Wafer Box Of 100
244.6 out of 5 Stars. 24 reviews
Water-Supply Engineering; the Designing, Construction, and Maintenance of Water-Supply Systems: Both City and Irrigation (Paperback)

Water-Supply Engineering; the Designing, Construction, and Maintenance of Water-Supply Systems: Both City and Irrigation (Paperback)
Save with
Consumption; Its Nature, Causes, Prevention and Cure (Hardcover) $32.94

$3294
current price $32.94Consumption; Its Nature, Causes, Prevention and Cure (Hardcover)
The Rights and Remedies of Creditors Respecting Their Debtor's Property (Hardcover)

2 options
Available in additional 2 optionsThe Rights and Remedies of Creditors Respecting Their Debtor's Property (Hardcover)
Save with
Ralph Shepard, Puritan, (Paperback) From $24.64

From$2464
Ralph Shepard, Puritan, (Paperback)
Save with
European Metals in Native Hands : Rethinking Technological Change 1640-1683 (Edition 1) (Paperback) $42.02

$4202
current price $42.02European Metals in Native Hands : Rethinking Technological Change 1640-1683 (Edition 1) (Paperback)
Of Revelation and Revolution, Volume 2 : The Dialectics of Modernity on a South African Frontier (Paperback) $45.93

$4593
current price $45.93Of Revelation and Revolution, Volume 2 : The Dialectics of Modernity on a South African Frontier (Paperback)
Prayers for Eventide (Paperback) From $15.95

From$1595
Prayers for Eventide (Paperback)
Save with
Pre-Owned Conspicuous Consumption: Unproduction Consumption of Goods Is Honourable (Penguin Great Ideas) (Paperback) 0143037595 9780143037590 $15.28

$1528
current price $15.28Pre-Owned Conspicuous Consumption: Unproduction Consumption of Goods Is Honourable (Penguin Great Ideas) (Paperback) 0143037595 9780143037590
Middle Ages Household Goods and Good Households in Late Medieval London: Consumption and Domesticity After the Plague, (Paperback) $32.77

$3277
current price $32.77Middle Ages Household Goods and Good Households in Late Medieval London: Consumption and Domesticity After the Plague, (Paperback)
Food Consumption (Hardcover) $30.10 Was $50.07

Now$3010
current price Now $30.10, Was $50.07$50.07
Food Consumption (Hardcover)
Pre-Owned Rainbow Magic the Petal Fairies: Louise the Lily Fairy (Paperback) 0545169925 9780545169929

Pre-Owned Rainbow Magic the Petal Fairies: Louise the Lily Fairy (Paperback) 0545169925 9780545169929
California World History Library: Domesticating the World : African Consumerism and the Genealogies of Globalization (Series #6) (Edition 1) (Paperback) $19.93

$1993
current price $19.93California World History Library: Domesticating the World : African Consumerism and the Genealogies of Globalization (Series #6) (Edition 1) (Paperback)
Save with
Information Policy: Virtual Economies : Design and Analysis (Paperback)

Information Policy: Virtual Economies : Design and Analysis (Paperback)
Save with
Consumption : Its Nature, Prevention, and Homopathic Treatment $21.59

$2159
current price $21.59Consumption : Its Nature, Prevention, and Homopathic Treatment
Objectifying China, Imagining America : Chinese Commodities in Early America (Paperback) $38.71

$3871
current price $38.71Objectifying China, Imagining America : Chinese Commodities in Early America (Paperback)
Pre-Owned Conspicuous Consumption: Unproduction Consumption of Goods Is Honourable (Penguin Great Ideas) (Paperback) 0143037595 9780143037590 $15.25

$1525
current price $15.25Pre-Owned Conspicuous Consumption: Unproduction Consumption of Goods Is Honourable (Penguin Great Ideas) (Paperback) 0143037595 9780143037590
A History of the Jewish People in the Time of Jesus Christ .. pt.1; Volume 2, (Paperback) From $24.95

From$2495
A History of the Jewish People in the Time of Jesus Christ .. pt.1; Volume 2, (Paperback)
Save with
Consumption: its Pathology and Treatment, (Hardcover) $59.90

$5990
current price $59.90Consumption: its Pathology and Treatment, (Hardcover)
Save with
Pre-Owned France Overseas: Studies in Empire and Decolonization: French St. Louis : Landscape, Contexts, and Legacy (Paperback) $35.52

$3552
current price $35.52Pre-Owned France Overseas: Studies in Empire and Decolonization: French St. Louis : Landscape, Contexts, and Legacy (Paperback)
Consumer Culture : Consumer Culture, Second Edition (Edition 2) (Paperback)

Consumer Culture : Consumer Culture, Second Edition (Edition 2) (Paperback)
California World History Library: Domesticating the World : African Consumerism and the Genealogies of Globalization (Series #6) (Edition 1) (Hardcover) $85.01

$8501
current price $85.01California World History Library: Domesticating the World : African Consumerism and the Genealogies of Globalization (Series #6) (Edition 1) (Hardcover)
Pre-Owned Culture and Consumption: New Approaches to the Symbolic Character of Consumer Goods and Activities (Paperback) 0253206286 9780253206282 $4.36

$436
current price $4.36Pre-Owned Culture and Consumption: New Approaches to the Symbolic Character of Consumer Goods and Activities (Paperback) 0253206286 9780253206282
Series in Victorian Studies: Textile Orientalisms : Cashmere and Paisley Shawls in British Literature and Culture (Hardcover) $84.29 Was $99.89

Now$8429
current price Now $84.29, Was $99.89$99.89
Series in Victorian Studies: Textile Orientalisms : Cashmere and Paisley Shawls in British Literature and Culture (Hardcover)
What Is Political Economy?: Consumption (Hardcover) $53.04

$5304
current price $53.04What Is Political Economy?: Consumption (Hardcover)
Making IT : The Rise of Asia in High Tech (Paperback) $25.00

$2500
current price $25.00Making IT : The Rise of Asia in High Tech (Paperback)
Save with
Dance, Consumerism, and Spirituality, (Hardcover) $54.99

$5499
current price $54.99Dance, Consumerism, and Spirituality, (Hardcover)
Save with
Frontiers of Political Economy (Paperback) $30.28

$3028
current price $30.28Frontiers of Political Economy (Paperback)
Consumption (Book I): Memories of My Childhood, (Hardcover) $46.23

$4623
current price $46.23Consumption (Book I): Memories of My Childhood, (Hardcover)
Consumption : Its Early and Remediable Stages $39.56

$3956
current price $39.56Consumption : Its Early and Remediable Stages
Middle Ages Household Goods and Good Households in Late Medieval London: Consumption and Domesticity After the Plague, (Hardcover) $61.62

$6162
current price $61.62Middle Ages Household Goods and Good Households in Late Medieval London: Consumption and Domesticity After the Plague, (Hardcover)
Save with
Consumption (Paperback) $18.75

$1875
current price $18.75Consumption (Paperback)
Rethink Consumption: How to Take Back Control of Your Consumer Behavior, (Paperback) $28.49

$2849
current price $28.49Rethink Consumption: How to Take Back Control of Your Consumer Behavior, (Paperback)
Save with
Pre-Owned Pikachu's Global Adventure : The Rise and Fall of Pokemon (Hardcover) $52.64

$5264
current price $52.64Pre-Owned Pikachu's Global Adventure : The Rise and Fall of Pokemon (Hardcover)
Consumption (Paperback) $6.99

$699
current price $6.99Consumption (Paperback)
Save with
Pre-Owned Between Mecca and Beijing : Modernization and Consumption Among Urban Chinese Muslims (Hardcover) $16.08

$1608
current price $16.08Pre-Owned Between Mecca and Beijing : Modernization and Consumption Among Urban Chinese Muslims (Hardcover)
Between Mecca and Beijing : Modernization and Consumption Among Urban Chinese Muslims (Paperback) $22.11

$2211
current price $22.11Between Mecca and Beijing : Modernization and Consumption Among Urban Chinese Muslims (Paperback)
Save with
Consumption: Its Cause and Nature, (Hardcover) $39.95

$3995
current price $39.95Consumption: Its Cause and Nature, (Hardcover)
Save with
Pre-Owned Middle Ages Household Goods and Good Households in Late Medieval London: Consumption and Domesticity After the Plague, (Hardcover) $82.07

$8207
current price $82.07Pre-Owned Middle Ages Household Goods and Good Households in Late Medieval London: Consumption and Domesticity After the Plague, (Hardcover)
Consumption, Its Prevention and Cure by the Water Treatment : With Advice Concerning Hemorrhage from the Lungs, Coughs, Colds, Asthma, Bronchitis, and Sore Throat $36.73

$3673
current price $36.73Consumption, Its Prevention and Cure by the Water Treatment : With Advice Concerning Hemorrhage from the Lungs, Coughs, Colds, Asthma, Bronchitis, and Sore Throat
Popular Culture Co-Productions and Collaborations in East and Southeast Asia (Paperback) $37.27

$3727
current price $37.27Popular Culture Co-Productions and Collaborations in East and Southeast Asia (Paperback)
Personal Care(14)
Dipsters Women's Bibb-Top with Shorts Patientwear, XX-Large $94.81

$9481
current price $94.81Dipsters Women's Bibb-Top with Shorts Patientwear, XX-Large
Save with
Natural Skin Care with Essential Oils : 30 Best Anti-Aging Homemade Products: (Healthy Skin Care, Homemade Skin Care) $8.99

$899
current price $8.99Natural Skin Care with Essential Oils : 30 Best Anti-Aging Homemade Products: (Healthy Skin Care, Homemade Skin Care)
Save with
List of Top 3 Bath and Body Products: User Guide for Bath and Body Products, (Paperback) $14.44

$1444
current price $14.44List of Top 3 Bath and Body Products: User Guide for Bath and Body Products, (Paperback)
Save with
Organic Beauty Products : Understand About Kinds Of Organic Beauty Care Products: Natural Skin Care At Home (Paperback) $14.34

$1434
current price $14.34Organic Beauty Products : Understand About Kinds Of Organic Beauty Care Products: Natural Skin Care At Home (Paperback)
Save with
Purely Natural Beauty & Bath Products: Make Simple, Safe, Organic, Vegan, Holistic, Eco-friendly Hygiene Products - , (Paperback) $12.85 Was $15.00

Now$1285
current price Now $12.85, Was $15.00$15.00
Purely Natural Beauty & Bath Products: Make Simple, Safe, Organic, Vegan, Holistic, Eco-friendly Hygiene Products - , (Paperback)
Save with
Pre-Owned The Aromatherapy Beauty Guide: Using the Science of Carrier and Essential Oils to Create Natural Personal Care Products (Paperback) 0778805603 9780778805601 Was $11.98

Pre-Owned The Aromatherapy Beauty Guide: Using the Science of Carrier and Essential Oils to Create Natural Personal Care Products (Paperback) 0778805603 9780778805601
Pre-Owned Pharma-Ecology : The Occurrence and Fate of Pharmaceuticals and Personal Care Products in the Environment (Hardcover) 9780470046302 $16.32

$1632
current price $16.32Pre-Owned Pharma-Ecology : The Occurrence and Fate of Pharmaceuticals and Personal Care Products in the Environment (Hardcover) 9780470046302
Pre-Owned Easy Beauty Recipes: Making Your Own Personal-Care Products in Minutes for Pennies (Paperback) 0824102983 9780824102982

Pre-Owned Easy Beauty Recipes: Making Your Own Personal-Care Products in Minutes for Pennies (Paperback) 0824102983 9780824102982
Pre-Owned Dying to Look Good: The Disturbing Truth About What's Really in Your Cosmetics, Toiletries and Personal Care Products Paperback From $6.42

From$642
Pre-Owned Dying to Look Good: The Disturbing Truth About What's Really in Your Cosmetics, Toiletries and Personal Care Products Paperback
A To Z Essential Guide To Skin Care- How Well Do You Know About The Ingredients In Every Beauty Product : Homemade Recipes For Skin (Paperback) $13.99

$1399
current price $13.99A To Z Essential Guide To Skin Care- How Well Do You Know About The Ingredients In Every Beauty Product : Homemade Recipes For Skin (Paperback)
Save with
Pre-Owned The Skin Type Solution: Are You Certain Tthat You Are Using the Optimal Skin Care Products? Revised andUpdated (Paperback) 0553383302 9780553383300

Pre-Owned The Skin Type Solution: Are You Certain Tthat You Are Using the Optimal Skin Care Products? Revised andUpdated (Paperback) 0553383302 9780553383300
Pre-Owned Surprising Starts of Health and Hygiene Products (Library Binding) 1668938243 9781668938249 $34.04
$3404
current price $34.04Pre-Owned Surprising Starts of Health and Hygiene Products (Library Binding) 1668938243 9781668938249
Pre-Owned Canadian Personal Care Provider, The (Paperback) 0132984679 9780132984676 $10.15

$1015
current price $10.15Pre-Owned Canadian Personal Care Provider, The (Paperback) 0132984679 9780132984676
Hair For Men Grow Hair Naturally with Diet Hygiene and Hair Products, (Paperback) $10.57

$1057
current price $10.57Hair For Men Grow Hair Naturally with Diet Hygiene and Hair Products, (Paperback)
Save with
Food & Beverages(1)
B & H Publishing Group 63429 Commun Fellowship Cup Prefilled Juice Wafer Box Of 100 $39.08

$3908
current price $39.08B & H Publishing Group 63429 Commun Fellowship Cup Prefilled Juice Wafer Box Of 100
244.6 out of 5 Stars. 24 reviews
Household Supplies(8)
ZORBX Unscented Odor Eliminator Spray for Hospitals & Healthcare Dog, Cat, Car & Carpet Deodorizer (16oz - Pack of 2) $29.97

$2997
current price $29.97ZORBX Unscented Odor Eliminator Spray for Hospitals & Healthcare Dog, Cat, Car & Carpet Deodorizer (16oz - Pack of 2)
13 out of 5 Stars. 1 reviews
Save with
APC - Heavy Duty All Purpose Cleaner & Degreaser

APC - Heavy Duty All Purpose Cleaner & Degreaser
Pre-Owned Rainbow Magic the Petal Fairies: Louise the Lily Fairy (Paperback) 0545169925 9780545169929

Pre-Owned Rainbow Magic the Petal Fairies: Louise the Lily Fairy (Paperback) 0545169925 9780545169929
Ralph Shepard, Puritan, (Paperback) From $24.64

From$2464
Ralph Shepard, Puritan, (Paperback)
Save with
Pet Supplies(16)
pink dog $14.95

$1495
current price $14.95pink dog
Save with
ZORBX Unscented Odor Eliminator Spray for Hospitals & Healthcare Dog, Cat, Car & Carpet Deodorizer (16oz - Pack of 2) $29.97

$2997
current price $29.97ZORBX Unscented Odor Eliminator Spray for Hospitals & Healthcare Dog, Cat, Car & Carpet Deodorizer (16oz - Pack of 2)
13 out of 5 Stars. 1 reviews
Save with
Prayers for Eventide (Paperback) From $15.95

From$1595
Prayers for Eventide (Paperback)
Save with
The Rights and Remedies of Creditors Respecting Their Debtor's Property (Hardcover)

2 options
Available in additional 2 optionsThe Rights and Remedies of Creditors Respecting Their Debtor's Property (Hardcover)
Save with
The Defensor Pacis of Marsiglio of Padua; Volume 8 (Paperback)

The Defensor Pacis of Marsiglio of Padua; Volume 8 (Paperback)
Save with
A History of the Jewish People in the Time of Jesus Christ .. pt.1; Volume 2, (Paperback) From $24.95

From$2495
A History of the Jewish People in the Time of Jesus Christ .. pt.1; Volume 2, (Paperback)
Save with
Water-Supply Engineering; the Designing, Construction, and Maintenance of Water-Supply Systems: Both City and Irrigation (Paperback)

Water-Supply Engineering; the Designing, Construction, and Maintenance of Water-Supply Systems: Both City and Irrigation (Paperback)
Save with
Journey to the North of India Arthur Conolly (Paperback) From $25.95

3 options
Available in additional 3 optionsFrom$2595
Journey to the North of India Arthur Conolly (Paperback)
Save with
Related Products
Pre-Owned Volatility in Indian and International Stock Markets (Paperback) 953078919X 9789530789197
Pre-Owned Volatility in Indian and International Stock Markets (Paperback) 953078919X 9789530789197$9.99current price $9.99Pre-Owned Prices in Financial Markets (Hardcover) 0195053125 9780195053128
Pre-Owned Prices in Financial Markets (Hardcover) 0195053125 9780195053128$7.10current price $7.10Pre-Owned Entry Strategies for International Markets (Hardcover) 0029269032 9780029269039
Pre-Owned Entry Strategies for International Markets (Hardcover) 0029269032 9780029269039$13.44current price $13.44Pre-Owned Marketing That Works: How Entrepreneurial Marketing Can Add Sustainable Value to Any Sized Company (Hardcover) 0133993337 9780133993332
Pre-Owned Marketing That Works: How Entrepreneurial Marketing Can Add Sustainable Value to Any Sized Company (Hardcover) 0133993337 9780133993332$7.09current price $7.09Pre-Owned Keep Innovation Simple - Paperback: Lead with Clarity and Focus in a World of Constant Change (Paperback) 0997202114 9780997202113
Pre-Owned Keep Innovation Simple - Paperback: Lead with Clarity and Focus in a World of Constant Change (Paperback) 0997202114 9780997202113$16.08current price $16.08Pre-Owned Training and entrepreneurship development in sericulture industry a case study of Belgaum division (Paperback) 6752731209 9786752731201
Pre-Owned Training and entrepreneurship development in sericulture industry a case study of Belgaum division (Paperback) 6752731209 9786752731201$10.00current price $10.00Pre-Owned An Introduction to International Capital Markets: Products, Strategies, Participants (Hardcover) 0470758988 9780470758984
Pre-Owned An Introduction to International Capital Markets: Products, Strategies, Participants (Hardcover) 0470758988 9780470758984$17.93current price $17.93Pre-Owned The Return of the State: And Why It Is Essential for Our Health, Wealth and Happiness (Hardcover) 0300256752 9780300256758
Pre-Owned The Return of the State: And Why It Is Essential for Our Health, Wealth and Happiness (Hardcover) 0300256752 9780300256758$25.43current price $25.43Pre-Owned The Leadership Crisis and the Free Market Cure: Why the Future of Business Depends on the Return to Life, Liberty, and the Pursuit of Happiness (Hardcover) 0071831118 9780071831116
Pre-Owned The Leadership Crisis and the Free Market Cure: Why the Future of Business Depends on the Return to Life, Liberty, and the Pursuit of Happiness (Hardcover) 0071831118 9780071831116$4.88current price $4.88














































